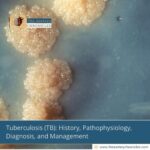
Tuberculosis-(TB):-History,-Pathophysiology,-Diagnosis,-and-Management-The-Aartery-Chronicles-TAC

Empowering Lives with Reliable Health Insights, Every Day.
- Career and Internships
Medical Writing & Journalism Internship
- Medical Journalism Course
Enroll Now for the Winter Batch!
Explore our Latest Articles...

New Study Reveals Hidden Danger in Psoriasis Patients
Reading Time: 2 minutesA new study reveals over 36%
Tuberculosis (TB): History, Pathophysiology, Diagnosis, and Management
Reading Time: 3 minutesComprehensive overview of tuberculosis: history, symptoms,

Doctor Found Dead in Goa Flat; Heart Attack Suspected
Reading Time: 3 minutesA Tamil Nadu doctor was found

Carbonated Chaas? You Need to Try This Now
Reading Time: 3 minutesCarbonated chaas? A yoghurt-based drink with

2025’s Corporate Crisis: The Rise of Revenge Quitting
Reading Time: 5 minutesRevenge quitting is the bold new

Study Finds Popular Fertility Pill May Harm Babies
Reading Time: 3 minutesFertility drug dydrogesterone is linked to

Mindfulness for Anxiety: Match the Right Practice to You
Reading Time: 4 minutesNot all anxiety is the same.

Wrinkly Fingers? It’s Not Water, It’s Your Nerves
Reading Time: 3 minutesThink wrinkly fingers are random? Think

Sweet Corn Chaat: Nutritious, Filling, and Full of Flavor
Reading Time: 2 minutesEnjoy this quick, healthy sweet corn
No Posts Found!
No Posts Found!
No Posts Found!
Explore Categories
- Blogs|
- Career Guide|
- Crime Insights|
- Dentistry|
- Editorial|
- Expert Insights|
- Fitness|
- Health Guide|
- Health News and Updates|
- Medicine and Diseases|
- Mental Health | Psychology|
- Nutrition and Diet|
- People Forum|
- Philosophy|

Reading Time: 2 minutesA new study reveals over 36% of psoriasis patients still have internal inflammation. Experts urge full-body care,...

Reading Time: 3 minutesComprehensive overview of tuberculosis: history, symptoms, diagnosis, types, treatment, and global impact of TB, including drug-resistant forms.

Reading Time: 3 minutesA Tamil Nadu doctor was found dead in a Goa flat. Police suspect heart disease as the...

Reading Time: 3 minutesCarbonated chaas? A yoghurt-based drink with soda, mint, and cucumber is trending online. Learn why it’s the...

Reading Time: 5 minutesRevenge quitting is the bold new workplace trend of 2025, driven by toxic culture, low pay, and...

Reading Time: 3 minutesFertility drug dydrogesterone is linked to more birth defects than other hormones used in pregnancy, says a...

Reading Time: 4 minutesNot all anxiety is the same. Learn how specific mindfulness techniques can ease your unique anxiety symptoms,...

Reading Time: 3 minutesThink wrinkly fingers are random? Think again. A study finds they’re controlled by nerves and may one...

Reading Time: 2 minutesEnjoy this quick, healthy sweet corn chaat recipe—packed with fiber, flavor, and perfect for a light snack...

Actor Fish Venkat Loses Life to Kidney Complications
Reading Time: 3 minutes Telugu actor Fish Venkat dies at 53 due to kidney failure. Known for comic roles, his loss is mourned by fans and the film industry.

15-Year-Old Girl Set on Fire in Odisha: What Happened?
Reading Time: 3 minutesA teen girl in Odisha was doused with petrol and set ablaze by three attackers. Police hunt continues as leaders demand justice and safety for women.

New Gene Discovery May Help Cure Vitamin D Deficiency
Reading Time: 3 minutesScientists discovered a gene, SDR42E1, vital for vitamin D absorption and cancer cell survival, offering hope for new treatments and precision medicine.

Prenatal Depression: What Every Expecting Mother Should Know
Reading Time: 4 minutesDepression during pregnancy can affect both mother and baby. Learn the symptoms, causes, and support options to manage it effectively.

Blood Sugar, Not Just Age, Linked to Male Sexual Decline
Reading Time: 2 minutesEven normal blood sugars can damage male fertility and erections. New findings reveal control of glucose may preserve men’s sexual health.

What Is Metabolic Syndrome? Causes, Risks & Prevention
Reading Time: 2 minutesLearn what metabolic syndrome is, its risk factors, and how diet, exercise, and lifestyle can help prevent this modern health condition.




